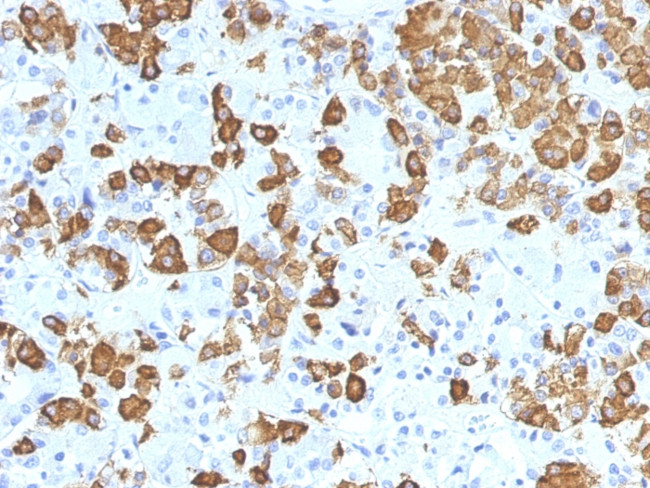
Growth Hormone Antibody in Immunohistochemistry (Paraffin) (IHC (P))

Search
NeoBiotechnologies
Growth Hormone Monoclonal Antibody (GH, 1371)
{{$productOrderCtrl.translations['antibody.pdp.commerceCard.promotion.promotions']}}
{{$productOrderCtrl.translations['antibody.pdp.commerceCard.promotion.viewpromo']}}
{{$productOrderCtrl.translations['antibody.pdp.commerceCard.promotion.promocode']}}: {{promo.promoCode}} {{promo.promoTitle}} {{promo.promoDescription}}. {{$productOrderCtrl.translations['antibody.pdp.commerceCard.promotion.learnmore']}}
产品信息
2688-MSM1-P1ABX
种属反应
宿主/亚型
分类
类型
克隆号
抗原
偶联物
形式
浓度
规格
纯化类型
保存液
内含物
保存条件
运输条件
产品详细信息
Immunohistochemistry (PFA fixed): incubate antibody for 30 min RT. Staining of formalin-fixed tissues requires heating tissue sections in 10mM Tris with 1mM EDTA, pH 9.0, for 45 min at 95 degrees C followed by cooling at RT for 20 minutes.
靶标信息
Human growth hormone (hGH) is a member of the somatotropin/prolactin family of hormones which play an important role in growth control. The GH1 gene, along with 4 additional related genes, is located at the growth hormone locus on chromosome 17. The five genes share a remarkably high degree of sequence identity. Alternative splicing results in 5 isoforms ranging from approximately 19 kDa to 24 kDa. HGH is produced by the somatotroph cells in the pituitary. It acts through binding to membrane receptors that belong to the cytokine receptor subfamily. Its major role in stimulating body growth is to stimulate the liver and other tissues to secrete IGF-1. It stimulates both the differentiation and proliferation of myoblasts. It also stimulates amino acid uptake and protein synthesis in muscle and other tissues. Mutations or deletions in the gene lead to growth hormone deficiency and short stature.
仅用于科研。不用于诊断过程。未经明确授权不得转售。
篇参考文献 (0)
生物信息学
蛋白别名: GH; GH1; Growth hormone; Growth hormone 1; growth hormone B5; HGH; Pituitary growth hormone; rHGH; Somatotropin; unnamed protein product
基因别名: GH; GH-N; GH1; GHB5; GHN; hGH-N; IGHD1A; IGHD1B; IGHD2
UniProt ID: (Human) P01241
Entrez Gene ID: (Human) 2688